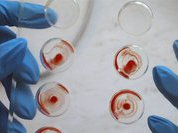
Свертываемость крови поставили на контроль

Россиян научат жить долго и счастливо?
 Профилактика
Профилактика
 Профилактика
Профилактика
По официальным данным в РФ 57% людей умирают от инсультов, тяжелая форма депрессии у 10% людей, от головной боли страдают 12% населения, деменция (слабоумие) – у 2 миллионов человек, болезнь Альцгеймера у 1,8 миллиона человек. Как остановить нарастающий процесс заболеваний мозга? Ученые готовы научить россиян жить до 120 лет, "выключая" болезни.
Предпочтения вегетарианцев - валерьянка с чесноком
 Диета
Диета
 Диета
Диета
В наши дни растет число людей, которые желают улучшить пищеварение и здоровье в целом. В этой связи потребители все чаще отдают предпочтение пробиотикам и пищевым ферментам в качестве пищевых добавок для поддержания здорового образа жизни. Ожидается, что мировые продажи пищевых добавок с пробиотиками за пять лет вырастут почти в два раза.
- Виноград от старости, баобаб для красоты
- Правильный матрас - залог крепкого сна
- Зачем нужно собирать почки
- Шов – дело тонкое. Молодые хирурги попробовали его освоить
- В Москве прошел конкурс "Мама рядом"
- "Мой ребенок плохо ест!"
- Творчество поставили на пользу здоровью
- Кардиоангиологи решили, как спасать от ампутации ноги у больных сахарным диабетом
- Синдром "сухого глаза" : Кто виноват, что слезы высохли? Изучение и лечение
- Витамины: не все так просто, как кажется
Ожирение: почему "яблоко" хуже "груши". Видео
 Профилактика
Профилактика
 Профилактика
Профилактика
Объем талии - важнейший показатель абдоминального ожирения, которое, кстати, врачи сегодня считают наиболее опасным среди всех его видов. Абдоминальное ожирение напрямую влияет и на здоровье
Весеннее питание: "зелень" с лица сотрет укроп
 Диета
Диета
 Диета
Диета
Уже показались первые теплые лучи солнца, в душе и на улице начинают петь птицы, а голова занята одним вопросом: "Как бы сбросить "зимние" килограммы?" И зеленоватый цвет лица не радует, да и во всем теле какая-то тяжесть… Питание сильно влияет на состояние нашего организма, а рацион, в свою очередь, должен меняться в зависимости от сезона.
Как бороться с весенней аллергией
 Профилактика
Профилактика
 Профилактика
Профилактика
Наступление весны неизменно радует нас теплом, солнцем и набухающими почками на деревьях. Но далеко не для всех это счастливый период. Для многих он может сопровождаться зудом, высыпаниями на коже, насморком и чиханием… Это коварная весенняя аллергия. Если ее невозможно избежать совсем, то как хотя бы минимизировать ущерб от этой напасти?
Свертываемость крови поставили на контроль
 Здоровье
Здоровье
Здоровье
Здоровье
В пятнадцати регионах России прошла Всероссийская социальная акция "День МНО".
- Тайны магния: зачем нам этот элемент?
- Когда мозг "тормозит", или Зачем нам сонные трубки
- Из-за чего зубы теряют белый цвет?
- Старческие недуги атакуют молодых
- Просыпаемся быстро и с удовольствием
- Эфирные масла: применяем в домашних условиях
- Медики и социологи выяснили, кто отвечает за здоровье россиян
- Фибрилляция предсердий: реальная угроза или миф?
- Эндометриоз - загадочный и только у женщин
- Женщины смогут больше узнать о своем здоровье

